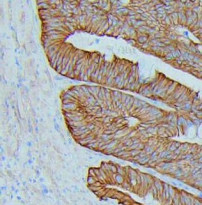

ARG44648
anti-delta 1 Catenin antibody
anti-delta 1 Catenin antibody for IHC-Formalin-fixed paraffin-embedded sections,Immunoprecipitation,Western blot and Human
Overview
| Product Description | Mouse Monoclonal antibody recognizes delta 1 Catenin |
|---|---|
| Tested Reactivity | Hu |
| Tested Application | IHC-P, IP, WB |
| Host | Mouse |
| Clonality | Monoclonal |
| Isotype | IgG2b |
| Target Name | delta 1 Catenin |
| Antigen Species | Human |
| Conjugation | Un-conjugated |
| Alternate Names | CTNND1; Catenin Delta 1; KIAA0384; P120cas; P120ctn; P120; Catenin (Cadherin-Associated Protein), Delta 1; Cadherin-Associated Src Substrate; Catenin Delta-1; P120 Catenin; CTNND; CAS; P120(CAS); P120(CTN); P120(Ctn); P120(Cas); BCDS2 |
Application Instructions
| Application Suggestion |
|
||||||||
|---|---|---|---|---|---|---|---|---|---|
| Application Note | * The dilutions indicate recommended starting dilutions and the optimal dilutions or concentrations should be determined by the scientist. |
Properties
| Form | Liquid |
|---|---|
| Purification | Protein A purification |
| Buffer | PBS with 0.09% sodium azide |
| Preservative | 0.09% sodium azide |
| Storage Instruction | For continuous use, store undiluted antibody at 2-8°C for up to a week. For long-term storage, aliquot and store at -20°C or below. Storage in frost free freezers is not recommended. Avoid repeated freeze/thaw cycles. Suggest spin the vial prior to opening. The antibody solution should be gently mixed before use. |
| Note | For laboratory research only, not for drug, diagnostic or other use. |
Bioinformation
| Database Links | |
|---|---|
| Gene Symbol | CTNND1 |
| Gene Full Name | Catenin Delta 1 |
| Background | This gene encodes a member of the Armadillo protein family, which function in adhesion between cells and signal transduction. Multiple translation initiation codons and alternative splicing result in many different isoforms being translated. Not all of the full-length natures of the described transcript variants have been determined. Read-through transcription also exists between this gene and the neighboring upstream thioredoxin-related transmembrane protein 2 (TMX2) gene. [provided by RefSeq, Dec 2010] |
| Function | Implicated both in cell transformation by SRC and in ligand-induced receptor signaling through the EGF, PDGF, CSF-1 and ERBB2 receptors. [UniProt] |
| Cellular Localization | Cell junction, Cell membrane, Cytoplasm, Membrane, Nucleus. [UniProt] |
| Calculated MW | 108 kDa |
| PTM | Acetylation, Isopeptide bond, Phosphoprotein, Ubl conjugation. [UniProt] |
Images (3) Click the Picture to Zoom In
-
ARG44648 anti-delta 1 Catenin antibody IHC-P image
Immunohistochemistry: Human Colon Adenocarcinoma stained with ARG44648 anti-delta 1 Catenin antibody at 2 µg/mL dilution.
-
ARG44648 anti-delta 1 Catenin antibody WB image
Western blot: Caco-2 stained with ARG44648 anti-delta 1 Catenin antibody at 1 µg/mL dilution.
-
ARG44648 anti-delta 1 Catenin antibody IP image
Immunoprecipitation: Caco-2 lysate immunoprecipitated with 2.5 µg of ARG44648 anti-delta 1 Catenin antibody.